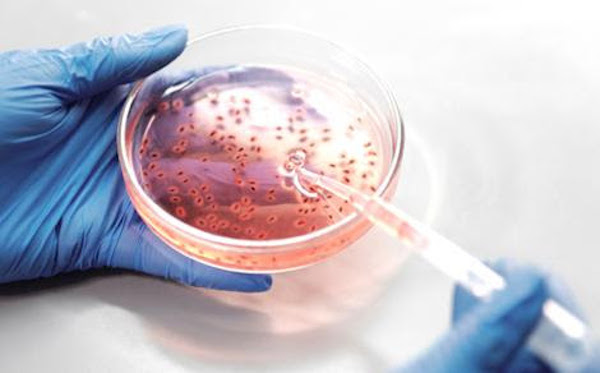
NOVAhealth Chronic Disease and Infection: Infection, Cancer and Global Health

The NOVA Saúde group in Chronic Diseases and Infection is launching its third international Conference with the general goal of fostering the discovery of novel scientific insights and the development of cross-disciplinary collaborations to shape research and the field.
This Conference has a broad focus in Infection, Cancer and Global health and invites all interested in any of these three main general topics. Special attention shall be given to factors that cause or prevent infection and cancer, their interplay and impact on global health.
NOVAhealth Chronic Disease and Infection Group is the convener of a set of scientific sessions to be held at Universidade NOVA de Lisboa.
The session will take place on October 9 of 2020, online, via the Zoom platform.
This international Workshop is for teaching staff, researchers and students at all levels. It aims to present research in a format that allows wide discussion among participants.
More information here.
Organizing Committee
Alexandra R Fernandes
UCIBIO, Departamento Ciências da Vida, FCT-NOVA
Paula Videira
UCIBIO, Departamento Ciências da Vida, FCT-NOVA
Helena Soares
Centro de Estudos de Doenças Crónicas, FCM | NMS
